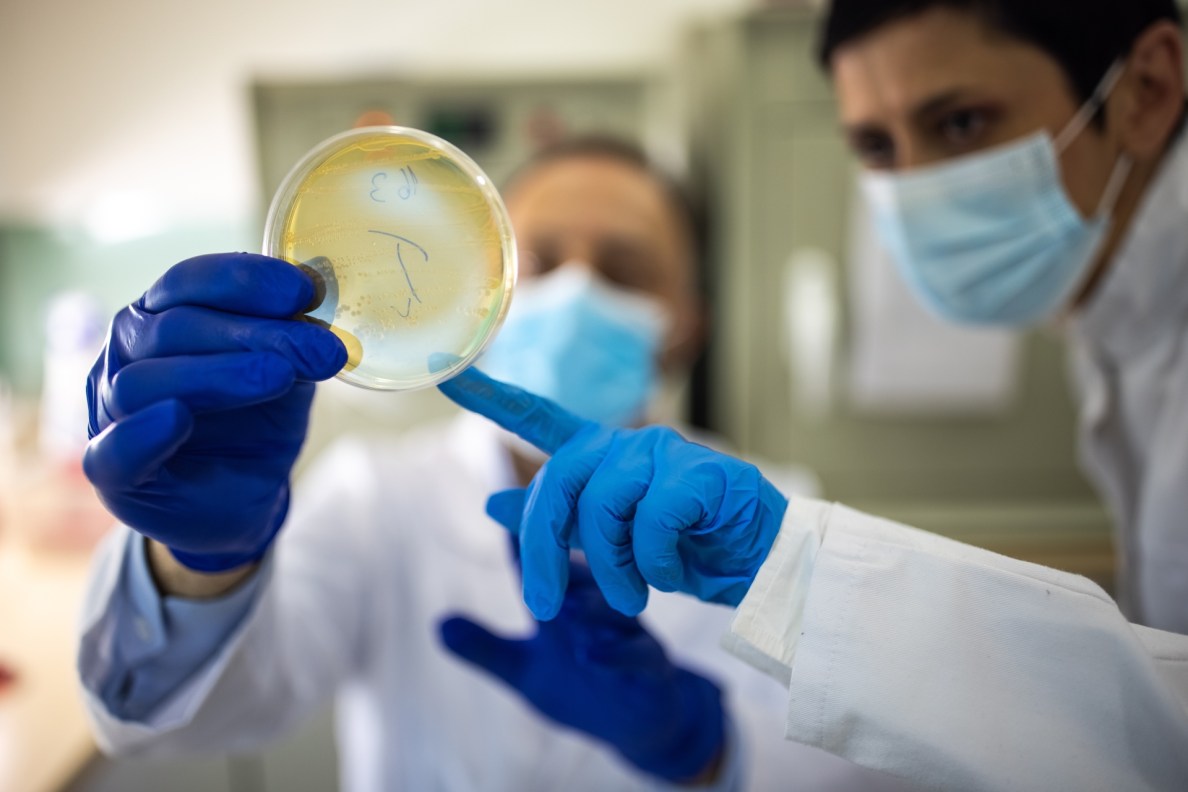
Two microbiologists with protective face masks looking at Petri dish in laboratory, focus on Petri dish
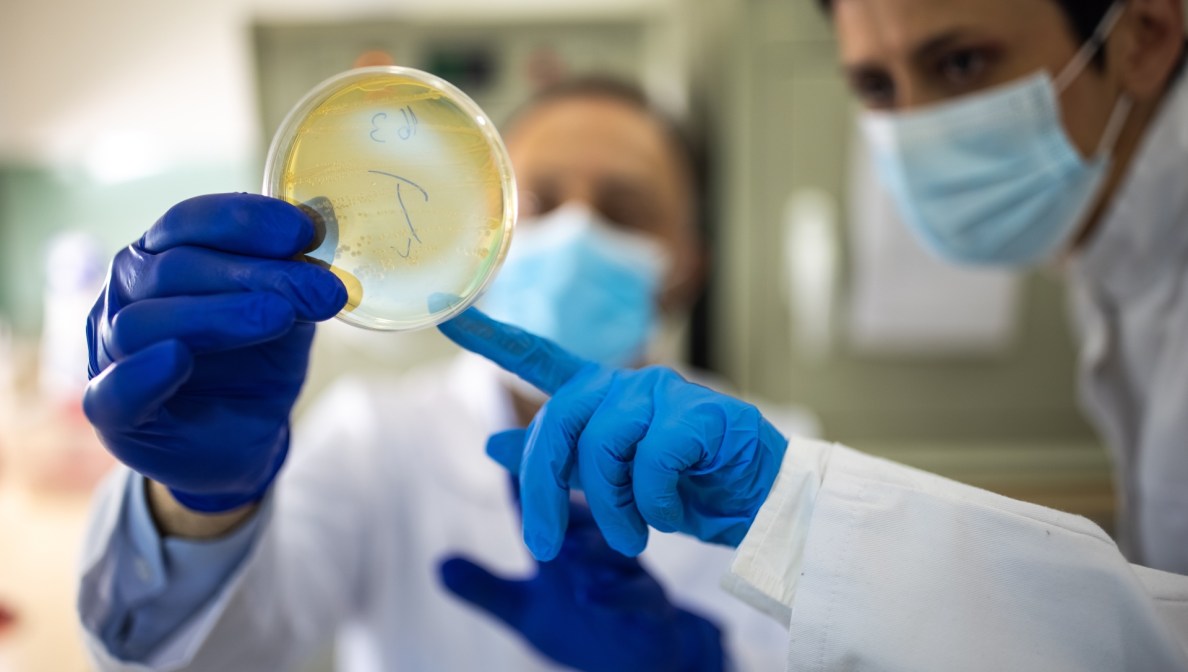
Two microbiologists with protective face masks looking at Petri dish in laboratory, focus on Petri dish

Antibiotikaresistenzen nehmen immer mehr zu. Als eines von wenigen Pharmaunternehmen setzt sich MSD dafür ein, dass auch in Zukunft wirkungsvolle Medikamente zur Verfügung stehen – durch eigene Forschung und die Unterstützung von Initiativen wie INCATE (INCubator for Antibacterial Therapies in Europe).
Die Weltgesundheitsorganisation (WHO) zählt Antibiotikaresistenzen (AMR: Antimicrobial Resistance) zu einer der zehn größten Gefahren für die öffentliche Gesundheit weltweit. Sie können dazu führen, dass bisher leicht zu behandelnde Infektionen nur noch schwer oder gar nicht mehr behandelt werden können. Um dem entgegenzuwirken, treibt MSD die Entwicklung neuer Antibiotika und Reserveantibiotika voran. Neben eigener Forschung unterstützen wir auch gemeinschaftliche Projekte wie den AMR Action Fund in den USA und den INCubator for Antibacterial Therapies in Europe (INCATE).
INCATE möchte Forschung, Industrie, erfahrene Unternehmer und Investoren aus ganz Europa zusammenbringen. Ziel ist es, Forschungsprojekte mit vielversprechenden Ansätzen zu fördern und so eine Pipeline an innovativen Medikamenten und besserer Diagnostik für die Zukunft aufzubauen. Denn die Schwierigkeit bei der medizinischen Entwicklung liegt nicht allein in der Grundlagenforschung, sondern vor allem darin, diese dann in Form von Arzneimitteln und Medizinprodukten zugänglich zu machen: Die gesetzlichen Regelungen sind umfassend und komplex, die Entwicklung insgesamt langwierig und kostenintensiv. Hier unterstützt INCATE einerseits finanziell, andererseits durch Beratung und Vernetzung innerhalb der Pharmabranche.
„Die COVID-19-Pandemie hat gezeigt, wie schnell wir Lösungen für drängende Gesundheitsprobleme finden können, wenn Forschung, Industrie und öffentliche Einrichtungen zusammenarbeiten“, sagt Sibyll Escher, Director Medical Affairs Infectious Disease bei MSD in Deutschland. „Genau das möchten wir mit INCATE auch für Antibiotikaresistenzen erreichen.“
INCATE ist im August 2021 gestartet. Unternehmen können sich laufend für eine Förderung bewerben. Ein Auswahlkomitee aus Expert:innen aus Industrie, Wissenschaft und öffentlichem Sektor wählt vierteljährlich Therapien und Diagnostika aus, die mit bis zu 10.000 Euro gefördert werden. Mehr zu INCATE und den Bewerbungsmodalitäten gibt es auf der Webseite der Initiative.
Weitere Informationen über Antibiotikaresistenzen gibt es bei uns im Blog.
Ihr Kontakt
Für weitere Informationen wenden Sie sich bitte an:
Charlotte Gerling
Sen. Specialist Corporate Communications